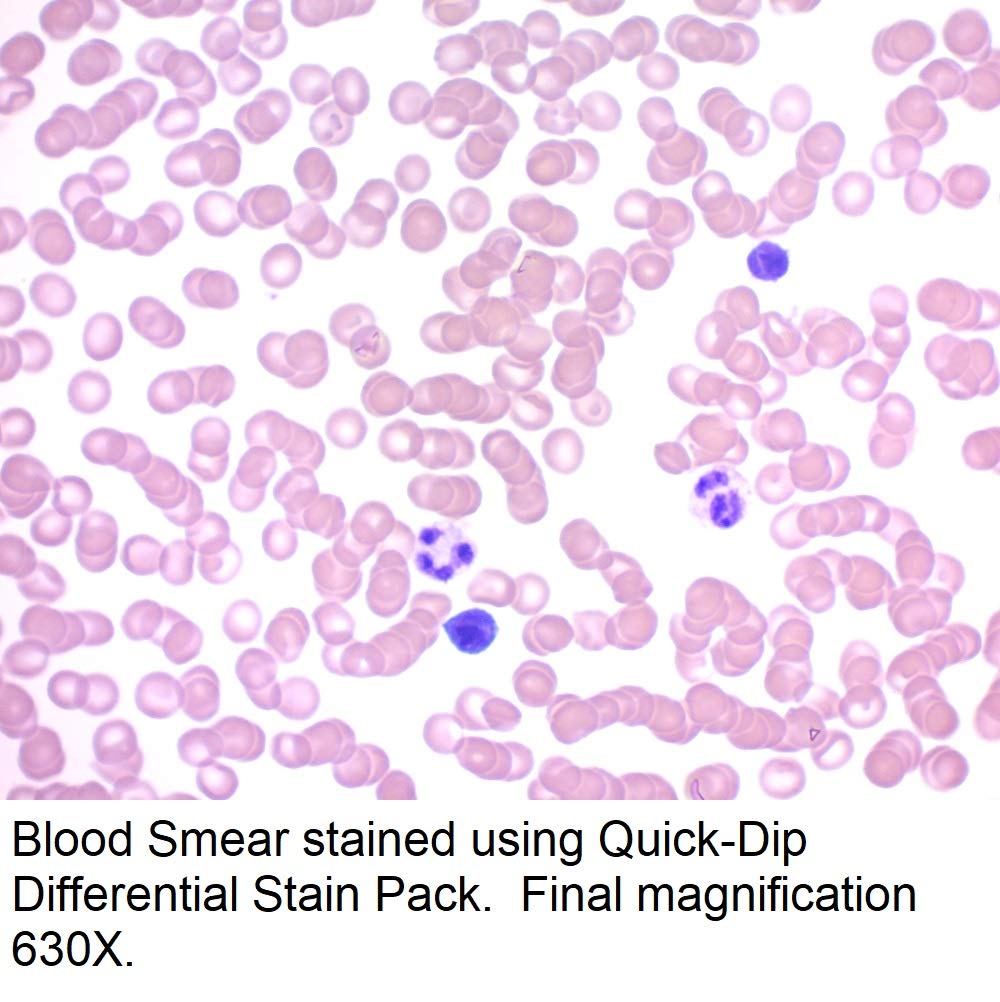

New
Arrivals/Restock
Quick-Dip Differential Stain Pack, 500ml
 Limited Time Sale
Limited Time SaleUntil the end
14
06
48
US$54.00 cheaper than the new price!!
Free shipping for purchases over $99 ( Details )
Free cash-on-delivery fees for purchases over $99
Free cash-on-delivery fees for purchases over $99
See all stores
Please note that the sales price and tax displayed may differ between online and in-store. Also, the product may be out of stock in-store.
Used US$36.00
Product details
| Management number | 211783808 | Release Date | 2026/04/04 | List Price | US$36.00 | Model Number | 211783808 | ||
|---|---|---|---|---|---|---|---|---|---|
| Category | |||||||||
Correction of product information
If you notice any omissions or errors in the product information on this page, please use the correction request form below.
Correction Request Form